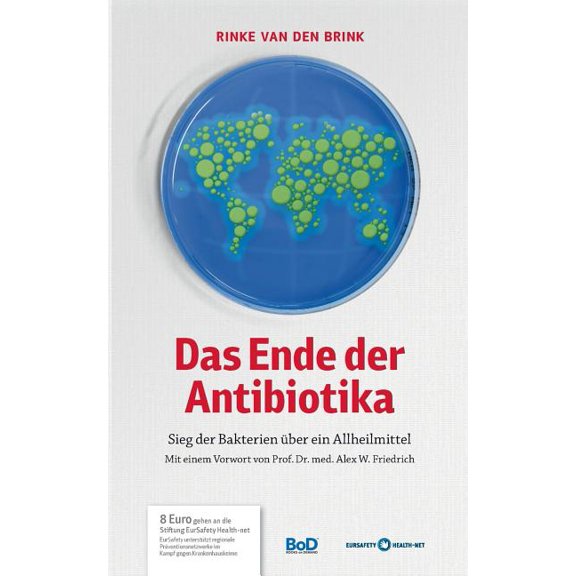
Das Ende der Antibiotika: Sieg der Bakterien über ein Allheilmittel, (Paperback)

Hero image 0 of Der politische Horizont des Babenbergers Leopold VI. (Paperback), 0 of 1
Price when purchased online
Not Available
How do you want your item?
Not available
About this item
Customer ratings & reviews
0 ratings|0 reviews
This item does not have any reviews yet
Related pages
- Adolf Friedrich Von 1815-1894 Schack; Juan Valera
- A Von Sternberg
- E I Du Pont De Nemours & Company
- Ciel Enterprises; Faizal Noorani
- F G Ghamsari
- Byzantine Empire History Books
- Middle Eastern Political Books
- Russian & Former Soviet Union Poetry Books
- Iran History Books
- Eu Fico Loko
- General Middle Eastern History Books
- Iraq Middle Eastern History Books